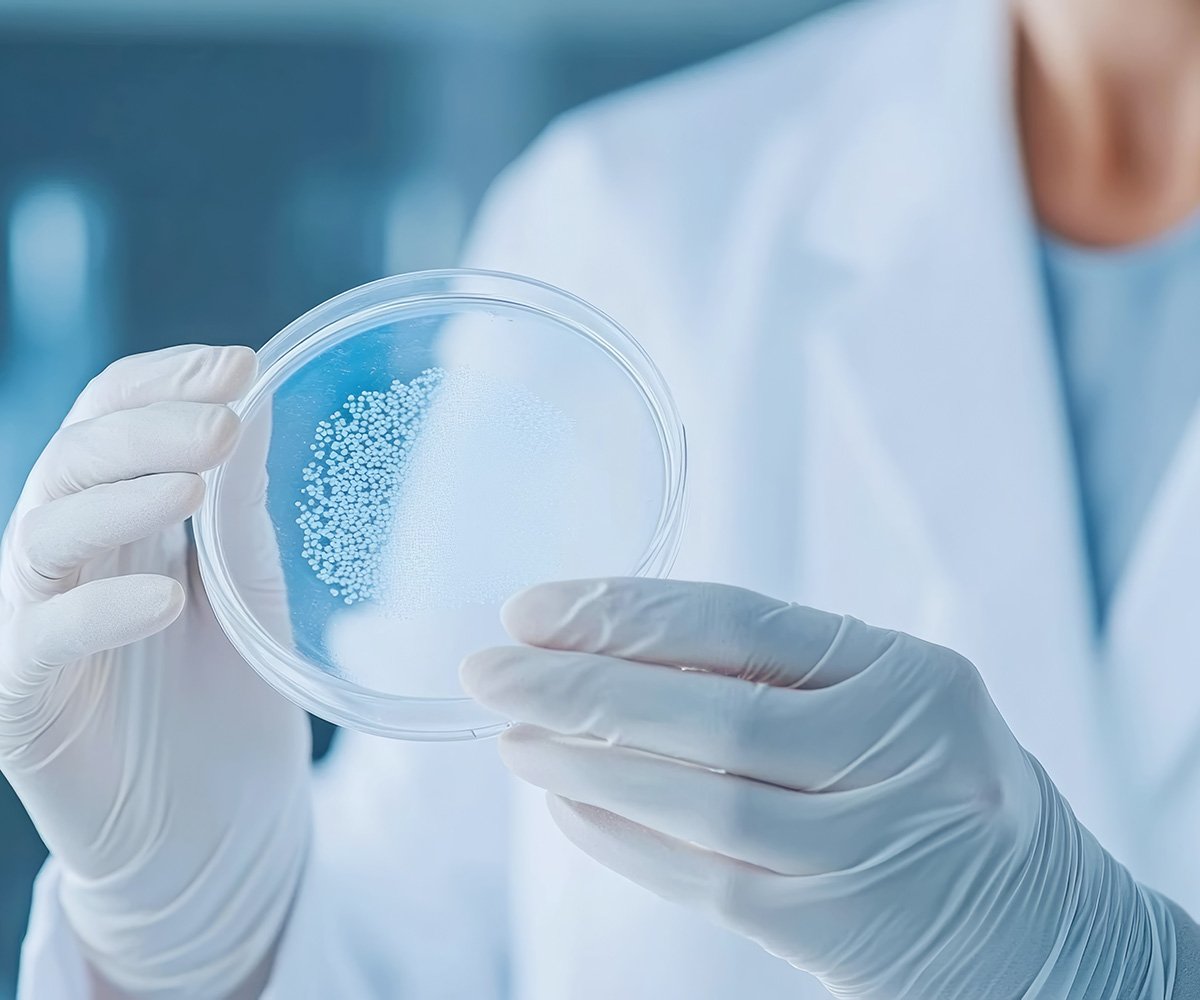
PB-TheSciencePage

Proprietary Functional Microbiome Insights for Innovation
Our Unique Scientific Approach
PhenoBiome’s proprietary platform is built on a strong foundation of 16+ years of research developed out of Sanford Burnham Prebys. Backed by a database of over 3,800 reference genomes, our proprietary technology translates complex microbiome sequencing data into clear, actionable insights for innovation. This essential intelligence reveals the functional root of microbial imbalances, empowering us to both quickly co-collaborate with partners on developing proprietary formulas and targeted interventions, or support our clinical partners with turnkey microbiome testing and precision nutraceuticals.
Highlights
- Team published in Nature, Science, NEJM
- Collaborations with world-leading microbiome researchers
- Leadership with multiple successful exits in healthcare and biotech
Functional Insights
We use our technology to precisely identify functional imbalances—such as issues with metabolic activity, nutrient metabolism, and vitamin synthesis—to determine their specific impact on the microbiome.
Holistic Community Analysis
Our intellectual property (IP) evaluates the collective phenotype of microbial communities, assessing how microbes interact and impact host health. This holistic view provides unique opportunities for comprehensive microbiome optimization that single-species analysis often misses.
Proprietary Formula Innovation
The unique power of our analysis is its ability to pinpoint the functional root cause microbiome imbalances. This level of precision enables us to develop formulations that specifically address these imbalances, effectively promoting underrepresented bacteria and increasing alpha diversity.
Clinical Validation
We ensure our solutions are grounded in results. Our clinical validation process consists of dedicated studies between 60 to 90 days to formally test and prove the efficacy of a developed formula or interventions. This rigorous approach provides our partners with the necessary data to support product claims and ensure market confidence.
